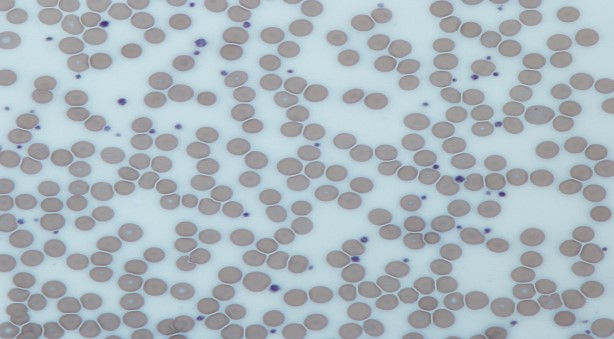

Ý nghĩa lâm sàng xét nghiệm máu toàn bộ (CBC)
Ý nghĩa lâm sàng xét nghiệm máu toàn bộ (CBC)
Xét nghiệm máu toàn bộ là một trong những xét nghiệm cơ bản nhất nhằm đánh giá sức khỏe tổng quát của một cá nhân cũng như hỗ trợ chẩn đoán các bệnh lý trong lâm sàng. Trong bản kết quả phân tích, xét nghiệm công thức máu toàn bộ cung cấp sự quan sát, phân loại và thống kê một cách toàn diện các tế bào máu đang lưu hành trong mạch máu của cơ thể.
- Xét nghiệm máu toàn bộ là gì?
Mặc dù không có hình thù, cấu trúc nhất định, máu vẫn được xem là một cơ quan và thuộc hệ cơ quan là hệ tuần hoàn. Sự liên kết của toàn bộ nội tạng trong cơ thể là nhờ vào sự hiện diện của máu. Thực vậy, vai trò của máu là đưa khí oxy và chất dinh dưỡng theo dòng động mạch cung cấp đến cho từng tế bào; đồng thời thu lại khí cacbonic và các sản phẩm thải ra từ những chuyển hóa nội ngoại bào theo dòng tĩnh mạch trở về tim. Không những thế, các tế bào máu còn đảm trách chức năng miễn dịch chống lại các tác nhân gây nhiễm trùng và đông máu, tránh chảy máu liên tục gây mất máu. Nói một cách khác, nếu máu bị bệnh, các hệ cơ quan khác cũng sẽ khó mà không bị ảnh hưởng gì.
Hai thành phần cấu tạo nên máu là bao gồm các tế bào máu và huyết tương. Theo đó, xét nghiệm công thức máu toàn bộ có nghĩa là cung cấp các thông tin sau khi khảo sát các loại tế bào máu trên các đặc điểm về số lượng, kích thước, hình thái của hồng cầu, bạch cầu và tiểu cầu. Ngược lại, các xét nghiệm thành phần huyết tương giúp đo lường các chất sinh hóa hòa tan lưu hành trong dòng máu.

Xét nghiệm máu toàn bộ giúp đánh giá trình trạng sức khỏe của bệnh nhân
- Khi nào cần thực hiện xét nghiệm máu toàn bộ?
Vì đây là cận lâm sàng cơ bản, xét nghiệm máu toàn bộ rất thường được chỉ định với những lý do sau đây:
- Đánh giá sức khỏe tổng quát của bạn: Ngay cả khi không mắc bệnh lý gì, trong mỗi lần khám sức khỏe định kỳ, bác sĩ đều chỉ định thực hiện làm công thức máu toàn bộ như là một tiêu chuẩn bắt buộc của kiểm tra y tế thông thường, qua đó nhằm để theo dõi sức khỏe tổng quát của bạn và sàng lọc nhiều loại rối loạn khác nhau trên các dòng tế bào máu, chẳng hạn như thiếu máu hoặc bệnh bạch cầu.
- Chẩn đoán bệnh lý hay một tình trạng y tế bất thường:Khi bạn đi khám vì mệt mỏi, suy nhược, sốt, viêm, có mảng bầm tím hoặc chảy máu tự nhiên, một xét nghiệm công thức máu toàn bộ có thể giúp chẩn đoán nguyên nhân của các dấu hiệu và triệu chứng này. Từ đó, bác sĩ có thể chẩn đoán và đưa ra các cách thức điều trị thích hợp.
- Theo dõi chiều hướng diễn tiến của một bệnh lý: Với một bệnh lý phức tạp, diễn tiến khó lường, kết quả công thức máu sẽ là một công cụ hỗ trợ bác sĩ theo dõi bệnh, đánh giá đáp ứng điều trị, điều chỉnh phác đồ cũng như phòng ngừa biến chứng có thể xảy ra.
- Thực hiện chỉ định truyền máu: Khi cơ thể bị mất máu cấp tính do chấn thương, tai nạn, xuất huyết tiêu hóa hay cơ thể thiếu máu do không tự sản xuất được trong bệnh lý suy tủy, ung thư máu, bạn có thể cần phải bồi đắp máu tối thiểu đủ các hệ cơ quan đảm bảo được chức năng của mình. Chỉ định truyền máu thường gặp nhất trong lâm sàng là truyền hồng cầu lắng, nhất là khi xuất huyết ồ ạt, ảnh hưởng huyết động.
Xét nghiệm máu khi khám sức khỏe tổng quát
- Ý nghĩa lâm sàng của xét nghiệm máu toàn bộ như thế nào?
Ý nghĩa lâm sàng của xét nghiệm máu toàn bộ ở một người lớn trưởng thành sẽ được phân tích theo từng dòng tế bào máu cụ thể sau đây:
3.1. Dòng tế bào hồng cầu
Dòng tế bào hồng cầu chứa các thông số quan trọng nhất trong bản kết quả công thức máu vì các tế bào này có số lượng nhiều nhất và đảm nhận chức năng chính yếu của máu.
Số lượng hồng cầu, huyết sắc tố và hematocrit là các chỉ số đặc trưng của dòng tế bào hồng cầu và có liên quan chặt chẽ với nhau. Đây là loại tế bào quy định màu sắc đỏ của máu và có chức năng chính là vận chuyển khí oxy từ phổi đến từng tế bào thực hiện chuyển hóa và nhận lại khí carbonic để thải ra phổi. Vì vậy, nếu lấy máu ở động mạch, máu sẽ có màu đỏ tươi vì đây là máu giàu oxi. Ngược lại, nếu lấy máu ở tĩnh mạch, máu sẽ có màu đỏ thẫm vì đây là máu nghèo oxi.
- Số lượng hồng cầu: Nam: 4.2 – 5.4 T/L. Nữ: 4.0 – 4.9 T/L
- Huyết sắc tố: Nam: 130 – 160 g/l. Nữ : 125 – 142 g/l
- Hematocrit: Nam: 0.42-0.47 L/L. Nữ : 0.37-0.42 L/L

Tế bào hồng cầu
Nếu lượng huyết sắc tố nhỏ hơn bình thường người bệnh sẽ được chẩn đoán là thiếu máu. Thiếu máu mạn tính gây ra mệt mỏi, suy nhược cơ thể và nguyên nhân thường gặp nhất là do thiếu sắt. Thiếu máu cấp tính thường xảy ra do chấn thương, chảy máu đường tiêu hóa… Bác sĩ sẽ cần xét nghiệm thêm để tìm nguyên nhân thiếu máu và có hướng điều trị thích hợp.
Trái lại, lượng huyết sắc tố hoặc hematocrit cao, đây có thể gợi ý một tình trạng bệnh lý tiềm ẩn, chẳng hạn như bệnh đa hồng cầu hoặc bệnh tim bẩm sinh, bệnh phổi mạn.
3.2. Dòng tế bào bạch cầu
Không giống như hồng cầu, dòng tế bào bạch cầu có màu trắng sữa. Đây là các tế bào tham gia vào hệ thống miễn dịch, bảo vệ cơ thể khỏi sự xâm nhập của vi khuẩn.
Số lượng bạch cầu: 4-10 G/L
Nếu kết quả xét nghiệm có số lượng bạch cầu của người bệnh cao hơn bình thường, người bệnh có thể đã bị nhiễm trùng hoặc viêm nhiễm, bác sĩ sẽ xem xét việc dùng thuốc kháng sinh. Tuy nhiên, nếu người bệnh hoàn toàn không có biểu hiện nhiễm trùng tại bất kỳ cơ quan nào nhưng chỉ số bạch cầu rất cao, cần nghi ngờ các tình trạng rối loạn hệ thống miễn dịch, các bệnh lý ác tính của cơ quan tạo máu. Ngoài ra, số lượng bạch cầu cao còn được ghi nhận là do phản ứng với một số loại thuốc nhất định.
Mặc dù vậy, nếu số lượng bạch cầu thấp thì vẫn được xem là một bệnh lý và cần theo dõi, chẳng hạn như các dạng rối loạn tự miễn làm phá hủy các tế bào bạch cầu, các vấn đề về tủy xương hoặc ung thư. Một số loại thuốc cũng có thể gây ức chế sản xuất bạch cầu. Trong những tình huống này, cơ thể sẽ không có khả năng đề kháng với các tác nhân gây bệnh từ môi trường do thiếu hụt bạch cầu. Khi nhiễm trùng trở nên nghiêm trọng, chỉ định truyền bạch cầu đôi khi cũng cần được xem xét.

Các loại tế bào bạch cầu
3.3. Dòng tế bào tiểu cầu
Có sự khác biệt rất lớn với dòng tế bào hồng cầu và dòng tế bào bạch cầu, tiểu cầu lại không phải là một tế bào máu thực sự mà là mảnh vỡ của một tế bào rất lớn, gọi là mẫu tiểu cầu. Đây là tế bào nằm trong tủy xương thay vì lưu thông trong lòng mạch như các tế bào máu khác. Chức năng của tiểu cầu là tham gia vào quá trình đông cầm máu ban đầu. Khi thành mạch bị vỡ, các tiểu cầu lập tức đến bám dính, tạo thành nút chặn, giúp máu giữ lại trong lòng mạch.
Số lượng tiểu cầu: 150 – 450 G/L
Theo đó, nếu số lượng tiểu cầu thấp hơn bình thường, chức năng đông cầm máu ban đầu không còn được đảm bảo, bạn sẽ có nguy cơ chảy máu tự phát hay chảy máu khó cầm. Giảm tiểu cầu thường là hậu quả sau nhiễm các loại siêu vi, nhất là sốt xuất huyết. Một số loại thuốc cũng có thể ảnh hưởng đến số lượng cũng như chức năng của tiểu cầu. Do đó, khi bệnh nhân sử dụng các loại thuốc này, việc xét nghiệm máu toàn bộ cũng là một điều cần thiết để theo dõi bệnh. Tuy nhiên, nếu giảm tiểu cầu lâu dài thì cần nghi ngờ các bệnh lý mạn tính như bệnh xơ gan, suy tủy hay ung thư máu gây ức chế tạo ra dòng tiểu cầu.
Ngược lại, nếu số lượng tiểu cầu cao hơn bình thường, thường là do các rối loạn nguyên phát trong quá trình tạo máu trong tủy xương, nguy cơ tắc mạch máu, tạo huyết khối trong lòng mạch sẽ tăng lên. Lúc này, người bệnh cần xem xét dùng các thuốc chống ngưng tập tiểu cầu.
Hình ảnh tế bào tiểu cầu
Tóm lại, xét nghiệm máu toàn bộ cung cấp một thông tin tổng quát về tình trạng các tế bào máu đang lưu hành trong lòng mạch. Nhờ đó, bác sĩ có thể đánh giá được sức khỏe toàn trạng của bạn cũng như phát hiện được rất nhiều bệnh lý, định hướng thêm các xét nghiệm để xác chẩn. Do đó, việc thăm khám định kỳ và thực hiện xét nghiệm máu toàn bộ là một hành động thiết thực quan tâm sức khỏe cho bạn và người thân.







